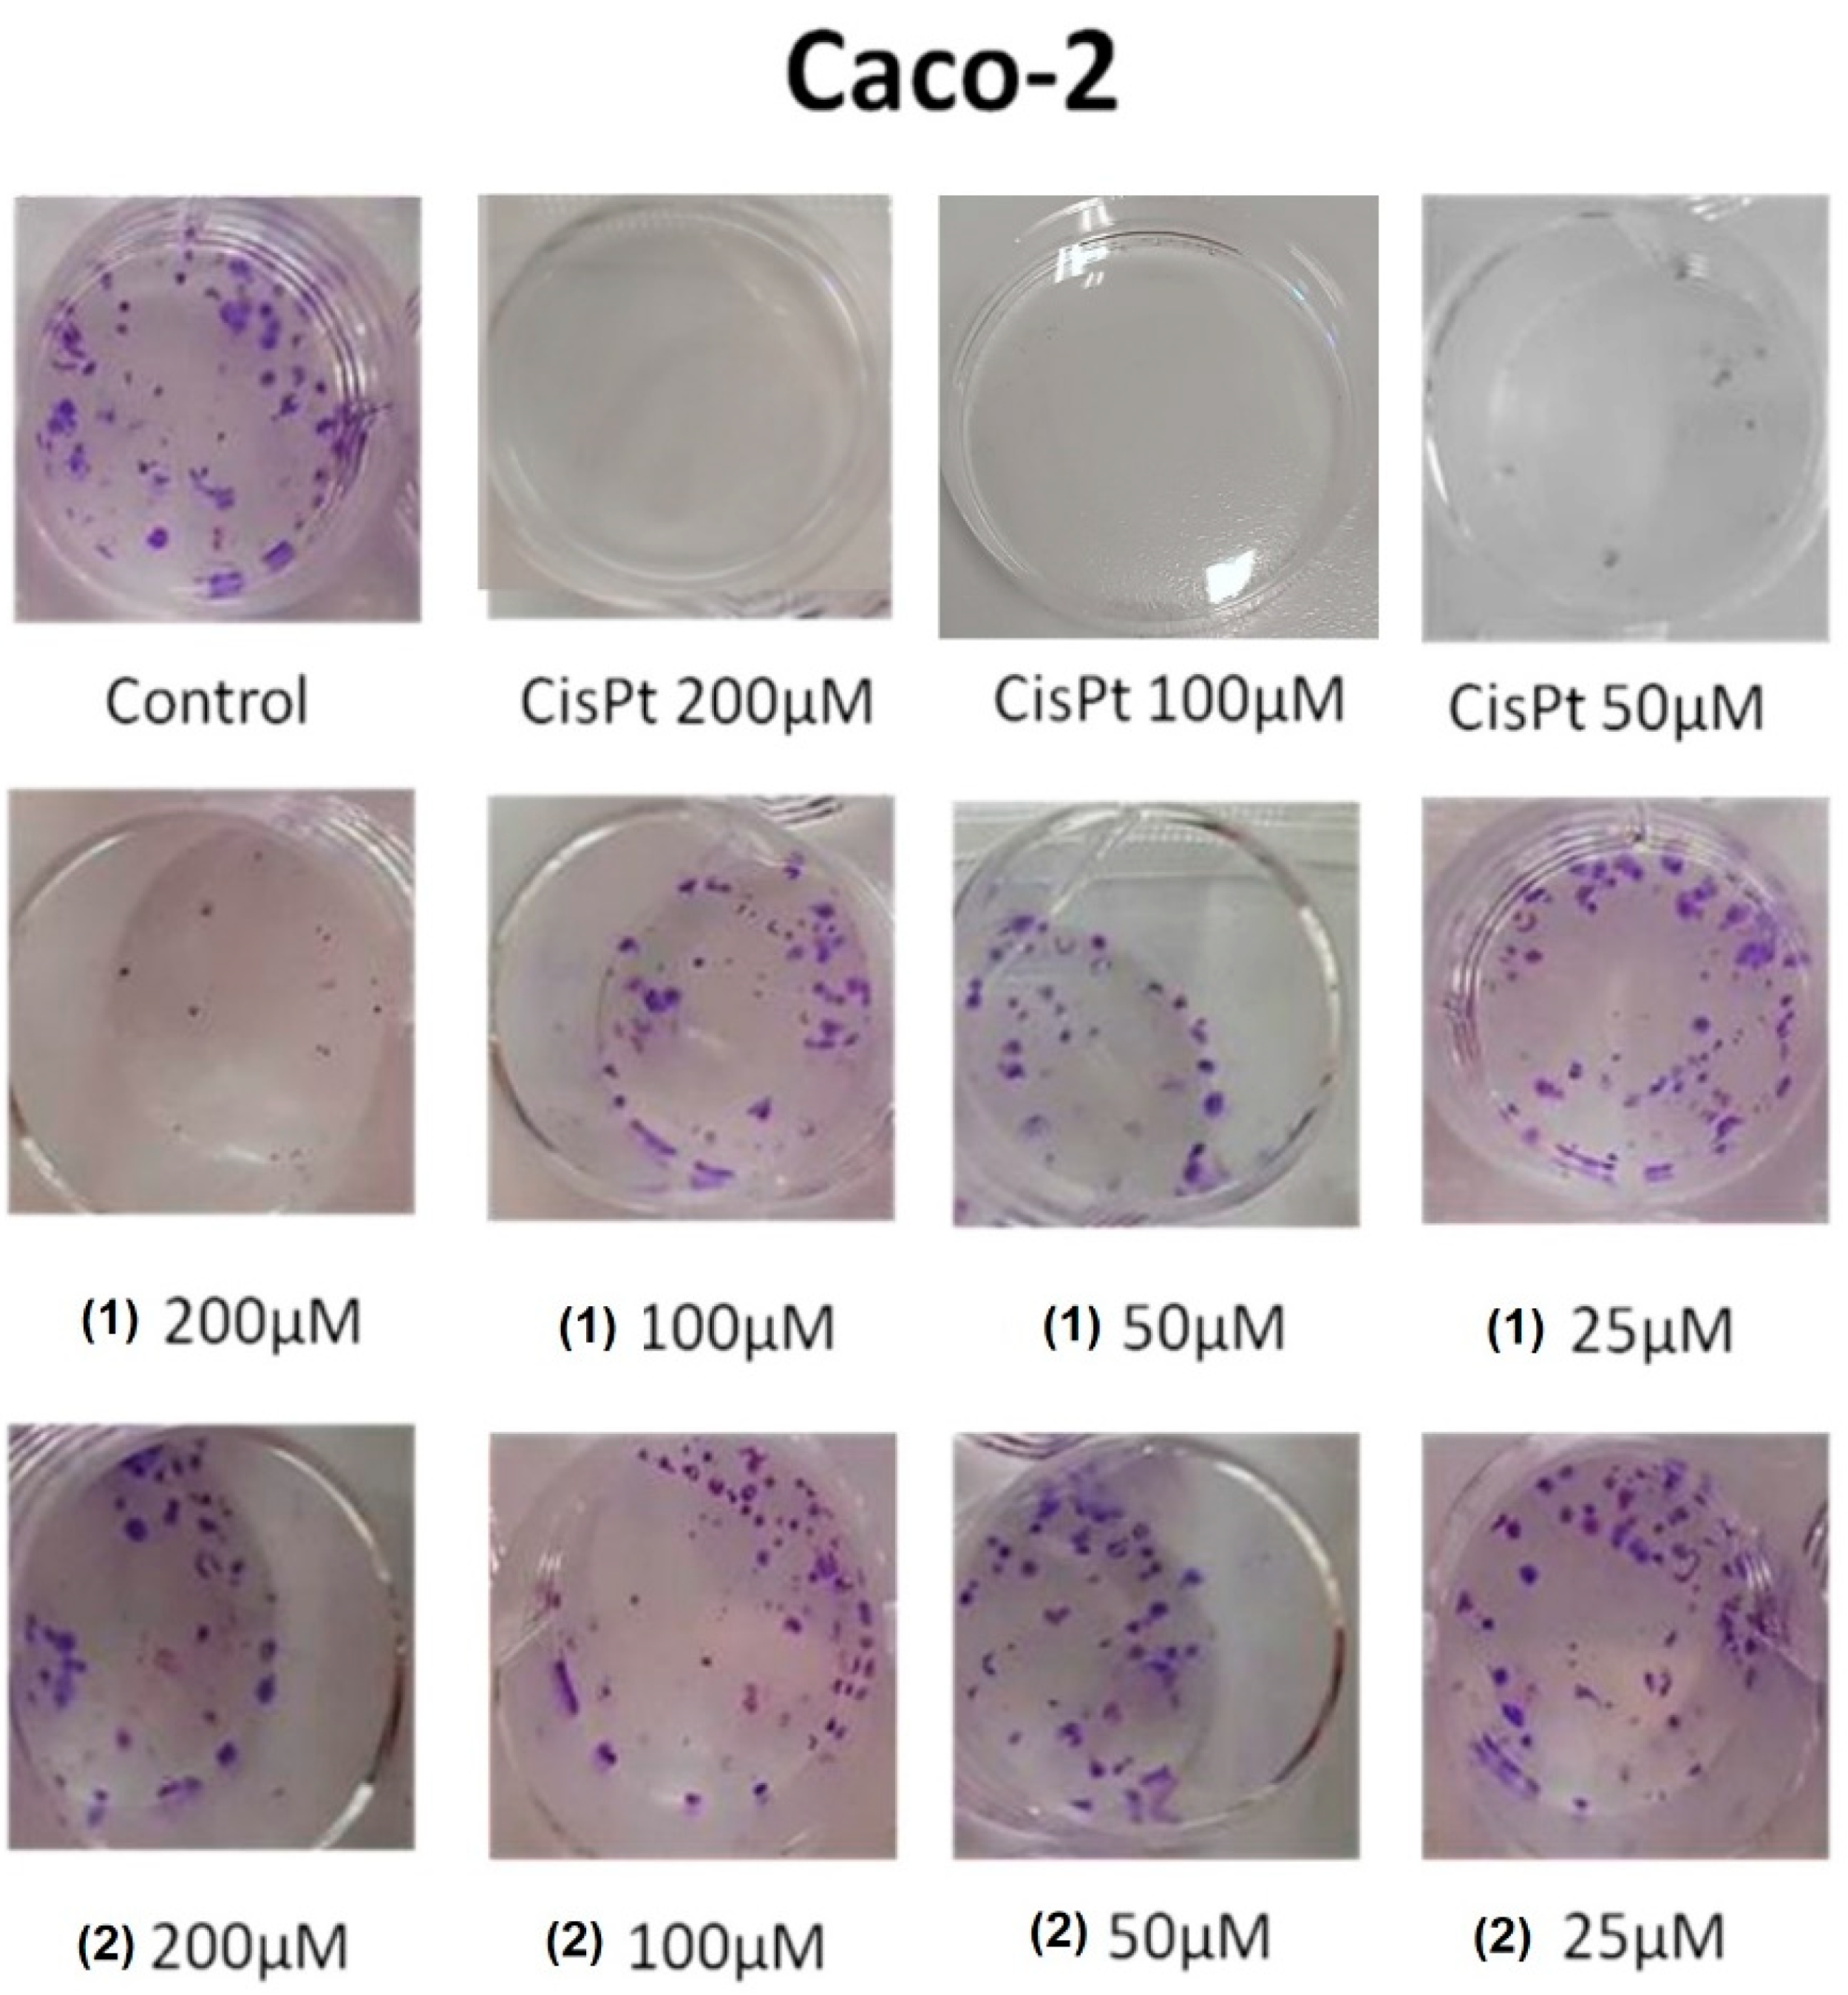
Applsci 12 07779 g008

Antiproliferative Activity of Aminobenzylnaphthols Deriving from the Betti Reaction
Abstract
:1. Introduction
2. Materials and Methods
2.1. Cell Cultures
2.2. Preparation of 1, 2, and Cisplatin Solutions
2.3. Study Design
2.4. In Vitro Cytotoxicity Test
2.4.1. Short-Term Studies: MTT Assay and Trypan Blue Exclusion Assay
2.4.2. Trypan Blue Assay
2.4.3. Long-Term Studies: Clonogenic Assay
2.5. Statistic Treatments
3. Results and Discussion
3.1. Cytotoxicity of 1 and 2 in Human Caco-2 Adenocarcinoma and SH-SY5Y Neuroblastoma Cells
3.2. Mitochondrial Function
3.3. Membrane Integrity
3.4. Colony-Forming Inhibition of Molecules 1 and 2 in Caco-2 Adenocarcinoma and SH-SY5Y Neuroblastoma Cells
3.5. Mechanistic Considerations
4. Conclusions
Author Contributions
Funding
Institutional Review Board Statement
Informed Consent Statement
Acknowledgments
Conflicts of Interest
References
- Duffy, M.J. The war on cancer: Are we winning? Tumor Biol. 2013, 34, 1275–1284. [Google Scholar] [CrossRef] [PubMed]
- Chen, S.H.; Chang, J.Y. New Insights into Mechanisms of Cisplatin Resistance: From Tumor Cell to Microenvironment. Int. J. Mol. Sci. 2019, 20, 4136. [Google Scholar] [CrossRef] [PubMed]
- Fatemeh, S.J.; Mostafa, S. Different profiles of the mRNA levels of DNA repair genes in MCF-7 and SH-SY5Y cells after treatment with combination of cisplatin, 50-Hz electromagnetic field and bleomycin. Biomed. Pharmacother. 2017, 94, 564–568. [Google Scholar] [CrossRef]
- Rabik, C.A.; Dolan, M.E. Molecular mechanisms of resistance and toxicity associated with platinating agents. Cancer Treat. Rev. 2007, 33, 9–23. [Google Scholar] [CrossRef] [PubMed]
- Culy, C.R.; Clemett, D.; Wiseman, L.R. Oxaliplatin. A review of its pharmacological properties and clinical efficacy in metastatic colorectal cancer and its potential in other malignancies. Drugs 2000, 60, 895–924. [Google Scholar] [CrossRef] [PubMed]
- Sun, Y.X.; Jian, Y.; Wang, P.Y.; Li, Y.J.; Xies, S.Y.; Sun, R.P. Cisplatin regulates SH-SY5Y cell growth through downregulation of BDNF via miR-16. Oncol. Rep. 2013, 30, 2343–2349. [Google Scholar] [CrossRef] [PubMed]
- Donzelli, E.; Carfì, M.; Miloso, M.; Strada, A.; Galbiati, S.; Bayssas, M.; Griffon-Etienne, G.; Cavaletti, G.; Petruccioli, M.G.; Tredici, G. Neurotoxicity of platinum compounds: Comparison of the effects of cisplatin and oxaliplatin on the human neuroblastoma cell line SH-SY5Y. J. Neurooncol. 2004, 67, 65–73. [Google Scholar] [CrossRef]
- Boccato, P.F.; Aleixo, N.A.; Nogueira, A.R.F.; Massabni, A.C. In vitro Studies of Antitumor Activity of Vanadium Complexes with Orotic and Glutamic Acids. Rev. Bras. Cancerol. 2020, 66, 4649. [Google Scholar] [CrossRef]
- Cardellicchio, C.; Capozzi, M.A.M.; Naso, F. The Betti base: The awakening of a sleeping beauty. Tetrahedron Asymmetry 2010, 21, 507–517. [Google Scholar] [CrossRef]
- Cardellicchio, C.; Ciccarella, G.F.; Schingaro, E.; Scordari, F. The Betti base: Absolute configuration and routes to a family of related chiral nonracemic bases. Tetrahedron Asymmetry 1998, 9, 3667–3675. [Google Scholar] [CrossRef]
- Cardellicchio, C.; Ciccarella, G.; Naso, F.; Perna, F.; Tortorella, P. Use of readily available chiral compounds related to the Betti base in the enantioselective addition of diethylzinc to aryl aldehydes. Tetrahedron 1999, 55, 14685–14692. [Google Scholar] [CrossRef]
- Cardellicchio, C.; Capozzi, M.A.M.; Alvarez-Larena, A.; Piniella, J.F.; Capitelli, F. Investigation on the weak interactions assembling the crystal structures of Betti bases. CrystEngComm 2012, 14, 3972–3981. [Google Scholar] [CrossRef]
- Capozzi, M.A.M.; Terraneo, G.; Cardellicchio, C. Structural insights into methyl- or methoxy-substituted 1-(a-aminobenzyl)-2-naphthol structures: The role of C-H···p interactions. Acta Cryst. 2019, C75, 189–195. [Google Scholar] [CrossRef]
- Capozzi, M.A.M.; Cardellicchio, C. Stereoselection in the Betti reaction of valine methyl esters. Tetrahedron Asymmetry 2017, 28, 1792–1796. [Google Scholar] [CrossRef]
- Capozzi, M.A.M.; Alvarez-Larena, A.; Piniella Febrer, J.F.; Cardellicchio, C. A combined structural and computational investigation of aminobenzylnaphthol compounds derived from the Betti reaction using valine methyl ester. New J. Chem. 2021, 45, 20735–20742. [Google Scholar] [CrossRef]
- Capozzi, M.A.M.; Capitelli, F.; Bottoni, A.; Calvaresi, M.; Cardellicchio, C. Stacked Naphthyls and Weak Hydrogen-Bond Interactions Govern the Conformational Behavior of P-Resolved Cyclic Phosphonamides: A Combined Experimental and Computational Study. J. Org. Chem. 2014, 79, 11101–11109. [Google Scholar] [CrossRef]
- Capozzi, M.A.M.; Pigliacelli, C.; Terraneo, G.; Cardellicchio, C. Stacked aryl groups in P-resolved cyclic phosphonamides as a new conformational constraint. CrystEngComm 2019, 21, 7224–7232. [Google Scholar] [CrossRef]
- Capozzi, M.A.M.; Cardellicchio, C.; Magaletti, A.; Bevilacqua, A.; Perricone, M.; Corbo, M.R. Bioactivity of a Family of Chiral Nonracemic Aminobenzylnaphthols towards Candida albicans. Molecules 2014, 19, 5219–5230. [Google Scholar] [CrossRef]
- Georgieva, N.V.; Yaneva, Z.L.; Simova, S.D.; Nikolova, G.D. Synthesis and properties of several Betti bases as potential drugs. Bulgar. Chem. Comm. 2017, 49, 201–208. [Google Scholar]
- Gyémánt, N.V.; Engi, H.; Schelz, Z.; Szatmári, I.; Tóth, D.; Fülöp, F.; Molnár, J.; de Witte, P.A.M. In vitro and in vivo multidrug resistance reversal activity by a Betti-base derivative of tylosin. Brit. J. Cancer 2010, 103, 178–185. [Google Scholar] [CrossRef]
- Iftikhar, R.; Kamran, M.; Iftikhar, A.; Parveen, S.; Naeem, N.; Jamil, N. Recent Advances in the green synthesis of Betti bases and their application: A review. Mol. Divers. 2022, 1–27. [Google Scholar] [CrossRef]
- Puerta, A.; Galán, A.R.; Abdilla, R.; Demanuele, K.; Fernandes, M.X.; Bosica, G.; Padrón, J.M. Naphthol-derived Betti bases as a potential SLC6A14 blockers. J. Mol. Clin. Med. 2019, 2, 35–40. [Google Scholar] [CrossRef]
- Yellapurkar, I.; Shaikh, S.; Pavale, G.; Bhabal, S.; Ramana, M.M.V. Kaolin-catalysed one-pot synthesis of thiophene containing aminonaphthols under solvent-free condition and their in vitro anticancer and antioxidant activity. Res. Chem. Interm. 2021, 47, 4067–4082. [Google Scholar] [CrossRef]
- Molnár, B.; Kinyua, N.I.; Mótyán, G.; Leits, P.; Zupkó, I.; Minorics, R.; Balogh, G.T.; Frank, E. Regioselective synthesis, physicochemical properties and anticancer activity of 2-aminomethylated estrone derivatives. J. Ster. Biochem. Mol. Biol. 2022, 219, 106064. [Google Scholar] [CrossRef]
- Dimić, D.S.; Kaluđerović, G.N.; Avdović, E.H.; Milenković, D.A.; Živanović, M.N.; Potocnak, I.; Samol’ova, E.; Dimitrijević, M.S.; Saso, L.; Marković, Z.S.; et al. Synthesis, Crystallographic, Quantum Chemical, Antitumor, and Molecular Docking/Dynamic Studies of 4-Hydroxycoumarin-Neurotransmitter Derivatives. Int. J. Mol. Sci. 2022, 23, 1001. [Google Scholar] [CrossRef]
- Nagaraju, B.; Kovvuri, J.; Kumar, C.G.; Routhu, S.R.; Shareef, M.A.; Kadagathur, M.; Adiyala, P.R.; Alavala, S.; Nagesh, N.; Kamal, A. Synthesis and biological evaluation of pyrazole linked benzothiazole-β-naphthol derivatives as topoisomerase I inhibitors with DNA binding ability. Bioorgan. Med. Chem. 2019, 27, 708–720. [Google Scholar] [CrossRef]
- Iftikhar, R.; Zahoor, A.F.; Irfan, M.; Rasul, A.; Rao, F. Synthetic molecules targeting yes associated protein activity as chemotherapeutics against cancer. Chem. Biol. Drug Des. 2021, 98, 1025–1037. [Google Scholar] [CrossRef]
- Karatas, H.; Akbarzadeh, M.; Adihou, H.; Hahne, G.; Pobbati, A.V.; Ng, E.Y.; Guéret, S.M.; Sievers, S.; Pahl, A.; Metz, M.; et al. Discovery of Covalent Inhibitors Targeting the Transcriptional Enhanced Associate Domain Central Pocket. J. Med. Chem. 2020, 63, 11972–11989. [Google Scholar] [CrossRef] [PubMed]
- Amitha, G.S.; Vasudevan, S. DNA binding and cleavage studies of novel Betti base substituted quaternary Cu(II) and Zn(II) phthalocyanines. Polyhedron 2020, 190, 114773. [Google Scholar] [CrossRef]
- Vale, N.; Ferreira, A.; Matos, J.; Fresco, P.; Gouveia, M.J. Amino Acids in the Developments of Prodrugs. Molecules 2018, 23, 2318. [Google Scholar] [CrossRef] [PubMed]
- Viswanathan, A.; Sebastianelli, G.; Brown, K.; Raunio, J.; Sipilä, V.; Yli-Harja, O.; Candeias, N.R.; Kandhavelu, M. In vitro anti-glioblastoma activity of L-valine derived boroxazolidones. Eur. J. Pharmac. 2019, 854, 194–200. [Google Scholar] [CrossRef]
- Lee, D.-Y.; Lin, H.-Y.; Ramasamy, M.; Kuo, S.-C.; Lee, P.-C.; Hsieh, M.-T. Synthesis and Characterization of the Ethylene-Carbonate-Linked L-Valine Derivatives of 4, 4-Dimethylcurcumin with Potential Anticancer Activity. Molecules 2021, 26, 7050. [Google Scholar] [CrossRef]
- Tsaousis, K.T.; Kopsachilis, N.; Tsinopoulos, I.T.; Dimitrakos, S.A.; Kruse, F.E.; Welge-Luessen, U. Time-dependent morphological alterations and viability of cultured human trabecular cells after exposure to Trypan blue. Clin. Exp. Ophthalmol. 2013, 41, 484–490. [Google Scholar] [CrossRef]
- Herzog, E.; Casey, A.; Lyng, F.M.; Chambers, G.; Byrne, H.J.; Davoren, M. A new approach to the toxicity testing of carbon-based nanomaterials—The clonogenic assay. Toxicol. Lett. 2007, 174, 49–60. [Google Scholar] [CrossRef]
- De Simone, U.; Manzo, L.; Ferrari, C.; Bakeine, J.; Locatelli, C.; Coccini, T. Short and long-term exposure of CNS cell lines to BPA-f a radiosensitizer for Boron Neutron Capture Therapy: Safety dose evaluation by a battery of cytotoxicity tests. Neurotoxicology 2013, 35, 84–90. [Google Scholar] [CrossRef]

| Cell Line | Cisplatin | 1 | 2 |
|---|---|---|---|
| Caco-2—24 h | 97 | 125 | 94 |
| Caco-2—72 h | 88 | 80 | 83 |
| SH-SY5Y—24 h | 88 | 80 | 182 |
| SH-SY5Y—72 h | 105 | 113 | 93 |
Publisher’s Note: MDPI stays neutral with regard to jurisdictional claims in published maps and institutional affiliations. |
© 2022 by the authors. Licensee MDPI, Basel, Switzerland. This article is an open access article distributed under the terms and conditions of the Creative Commons Attribution (CC BY) license (https://creativecommons.org/licenses/by/4.0/).
Share and Cite
Mallamaci, R.; Capozzi, M.A.M.; Cardellicchio, C. Antiproliferative Activity of Aminobenzylnaphthols Deriving from the Betti Reaction. Appl. Sci. 2022, 12, 7779. https://doi.org/10.3390/app12157779
Mallamaci R, Capozzi MAM, Cardellicchio C. Antiproliferative Activity of Aminobenzylnaphthols Deriving from the Betti Reaction. Applied Sciences. 2022; 12(15):7779. https://doi.org/10.3390/app12157779
Chicago/Turabian StyleMallamaci, Rosanna, Maria Annunziata M. Capozzi, and Cosimo Cardellicchio. 2022. "Antiproliferative Activity of Aminobenzylnaphthols Deriving from the Betti Reaction" Applied Sciences 12, no. 15: 7779. https://doi.org/10.3390/app12157779
APA StyleMallamaci, R., Capozzi, M. A. M., & Cardellicchio, C. (2022). Antiproliferative Activity of Aminobenzylnaphthols Deriving from the Betti Reaction. Applied Sciences, 12(15), 7779. https://doi.org/10.3390/app12157779








